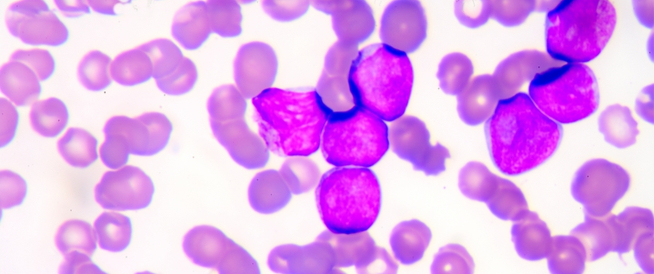
tbl_articles_article_27160_061459a3f-bd15-469a-a48f-622ea5d32478 الثلاسيميا الصغرى: دليلك الشامل

الثلاسيميا الصغرى: دليلك الشامل
تُعد الثلاسيميا الصغرى أحد أنواع ثلاسيميا بيتا، ولكن ما هي أعراضها؟ وهل يمكن علاجها؟ تابع قراءة المقال الآتي لتعرف الإجابة.
تعرف الثلاسيميا (Thalassemia) بأنها مجموعة من الاضطرابات الدموية الموروثة التي تنتج الهيموغلوبين بشكل غير صحيح، إذ تختلف أنواعها باختلاف الية الإنتاج، إليك هذا المقال لتتعرف على الثلاسيميا الصغرى كأحد أنواع الثلاسيميا:
الثلاسيميا الصغرى
الثلاسيميا الصغرى (Thalassemia minor) وهي أحد أنواع الثلاسيميا والتي تعد شكلًا موروثًا من أشكال فقر الدم الانحلالي (Hemolytic anemia)، وغالبًا ما تعد الثلاسيميا الصغرى أقل حدةً من بين أنواع الثلاسيميا.
تظهر عينة الدم لشخص مصاب بالثلاسيميا خلايا دم حمراء صغيرة الحجم (Microcytic) وناقصة الصباغ (Hypochromic)، ومن الجدير بالذكر أن خلايا الدم الحمراء صغيرة الحجم تحمل كميات من الأكسجين أقل من الخلايا ذات الحجم الطبيعي.
أعراض الثلاسيميا الصغرى
غالبًا لا يعاني مصاب الثلاسيميا الصغرى من ظهور أي أعراض، لكن في بعض الأحيان قد يعاني مصاب الثلاسيميا الصغرى من فقر دم بسيط على عكس الثلاسيميا الكبرى التي تظهر فيها أعراض شديدة تتطلب في بعض الأحيان إلى عمليات نقل الدم.
أسباب الإصابة بالثلاسيميا الصغرى
تحدث الإصابة بالثلاسيميا الصغرى نتيجة حدوث خلل في جين واحد فقط، لذا غالبًا ما يعاني المصاب من فقر دم أقل حدة من الأنواع الأخرى.
ومن الجدير بالذكر أنه يمكن تمرير هذا الجين لأطفال المصاب بنسبة 50%.
مضاعفات الثلاسيميا الصغرى
تعد الثلاسيميا الصغرى نوعًا خفيفًا من الثلاسيميا، فغالبًا لا تسبب أي من المشكلات أو المضاعفات على المدى البعيد، ولكن يجدر الإشارة بالذكر إلى أن مصاب الثلاسيميا الصغرى سيكون حاملًا لجين هذا المرض.
الفرق بين الثلاسيميا الصغرى والثلاسيميا الكبرى
تقسم الثلاسيميا بيتا (Beta Thalassemia) إلى نوعين، هما: الصغرى والكبرى، إذ يأتي الفرق بينهما كما يأتي:
1. الثلاسيميا الصغرى
يكون لدى المصاب نسخة واحدة فقط من جين الثلاسيميا، مع وجود انخفاض قليل في الهميوغلوبين ومستوى طبيعي من الحديد في الدم.
ومن الجدير بالذكر أنه لا يوجد علاج ضروري لمصاب الثلاسيميا الصغرى، وغالبًا لا ينصح باستخدام الحديد.
2. الثلاسيميا الكبرى
يكون المصاب حامل لجينان من جينات الثلاسيميا بيتا ولا يحمل الجين الطبيعي، وبالتالي فإنه يؤثر على إنتاج الهيموجلوبين بشكل كبير، لذا يعد الثلاسيميا الكبرى أحد الأمراض الخطيرة.
ويبدأ فقر الدم بالظهور خلال الأشهر الأولى بعد الولادة، والذي قد يسبب فشل في نمو الطفل وسوء التغذية وغيرها من المشكلات الخطيرة.
هل يمكنك الوقاية من الإصابة بالثلاسيميا؟
يعد مرض الثلاسيميا أحد الأمراض الموروثة، لذا فهو ينتقل من الاباء إلى الأبناء، ولا يمكن منع حدوث هذا الانتقال، لذا من الضروري استشارة طبيب مختص عند وجود إصابة بالثلاسيميا لدى العائلة لتحديد مدى مخاطر إصابة الأطفال بها.
كيف يمكن التعايش مع مرض الثلاسيميا؟
هناك بعض الممارسات اليومية التي ينصح باتباعها لمصاب الثلاسيميا للتقليل من خطر الإصابة بالمضاعفات الأخرى، نذكر منها ما يأتي:
- اتباع نظام صحي غذائي متوازن، حيث لا يحتاج هؤلاء المرضى إلى نظام غذائي خاص.
- الحرص على تناول المكملات الغذائية، مثل: الكالسيوم، وحمض الفوليك، وفيتامين د.
- ممارسة التمارين الرياضية بشكل منتظم، مثل: تمارين حمل الأوزان، والتمارين الهوائية، حيث تساعد في تقوية العظام ةتقليل خطر الإصابة بهشاشة العظام.
- تجنب التدخين والتوقف عن شرب الكحول.
- تجنب الإصابة بالعدوى، وذلك من خلال الحفاظ على النظافة الشخصية والتأكد من أخذ المطاعيم اللازمة، والابتعاد عن الأشخاص المصابين بالعدوى ونجنب التواصل المباشر معهم.
- التأكد من أخذ الأدوية كما يصفها الطبيب، وإجراء الفحوصات الدورية الهامة.